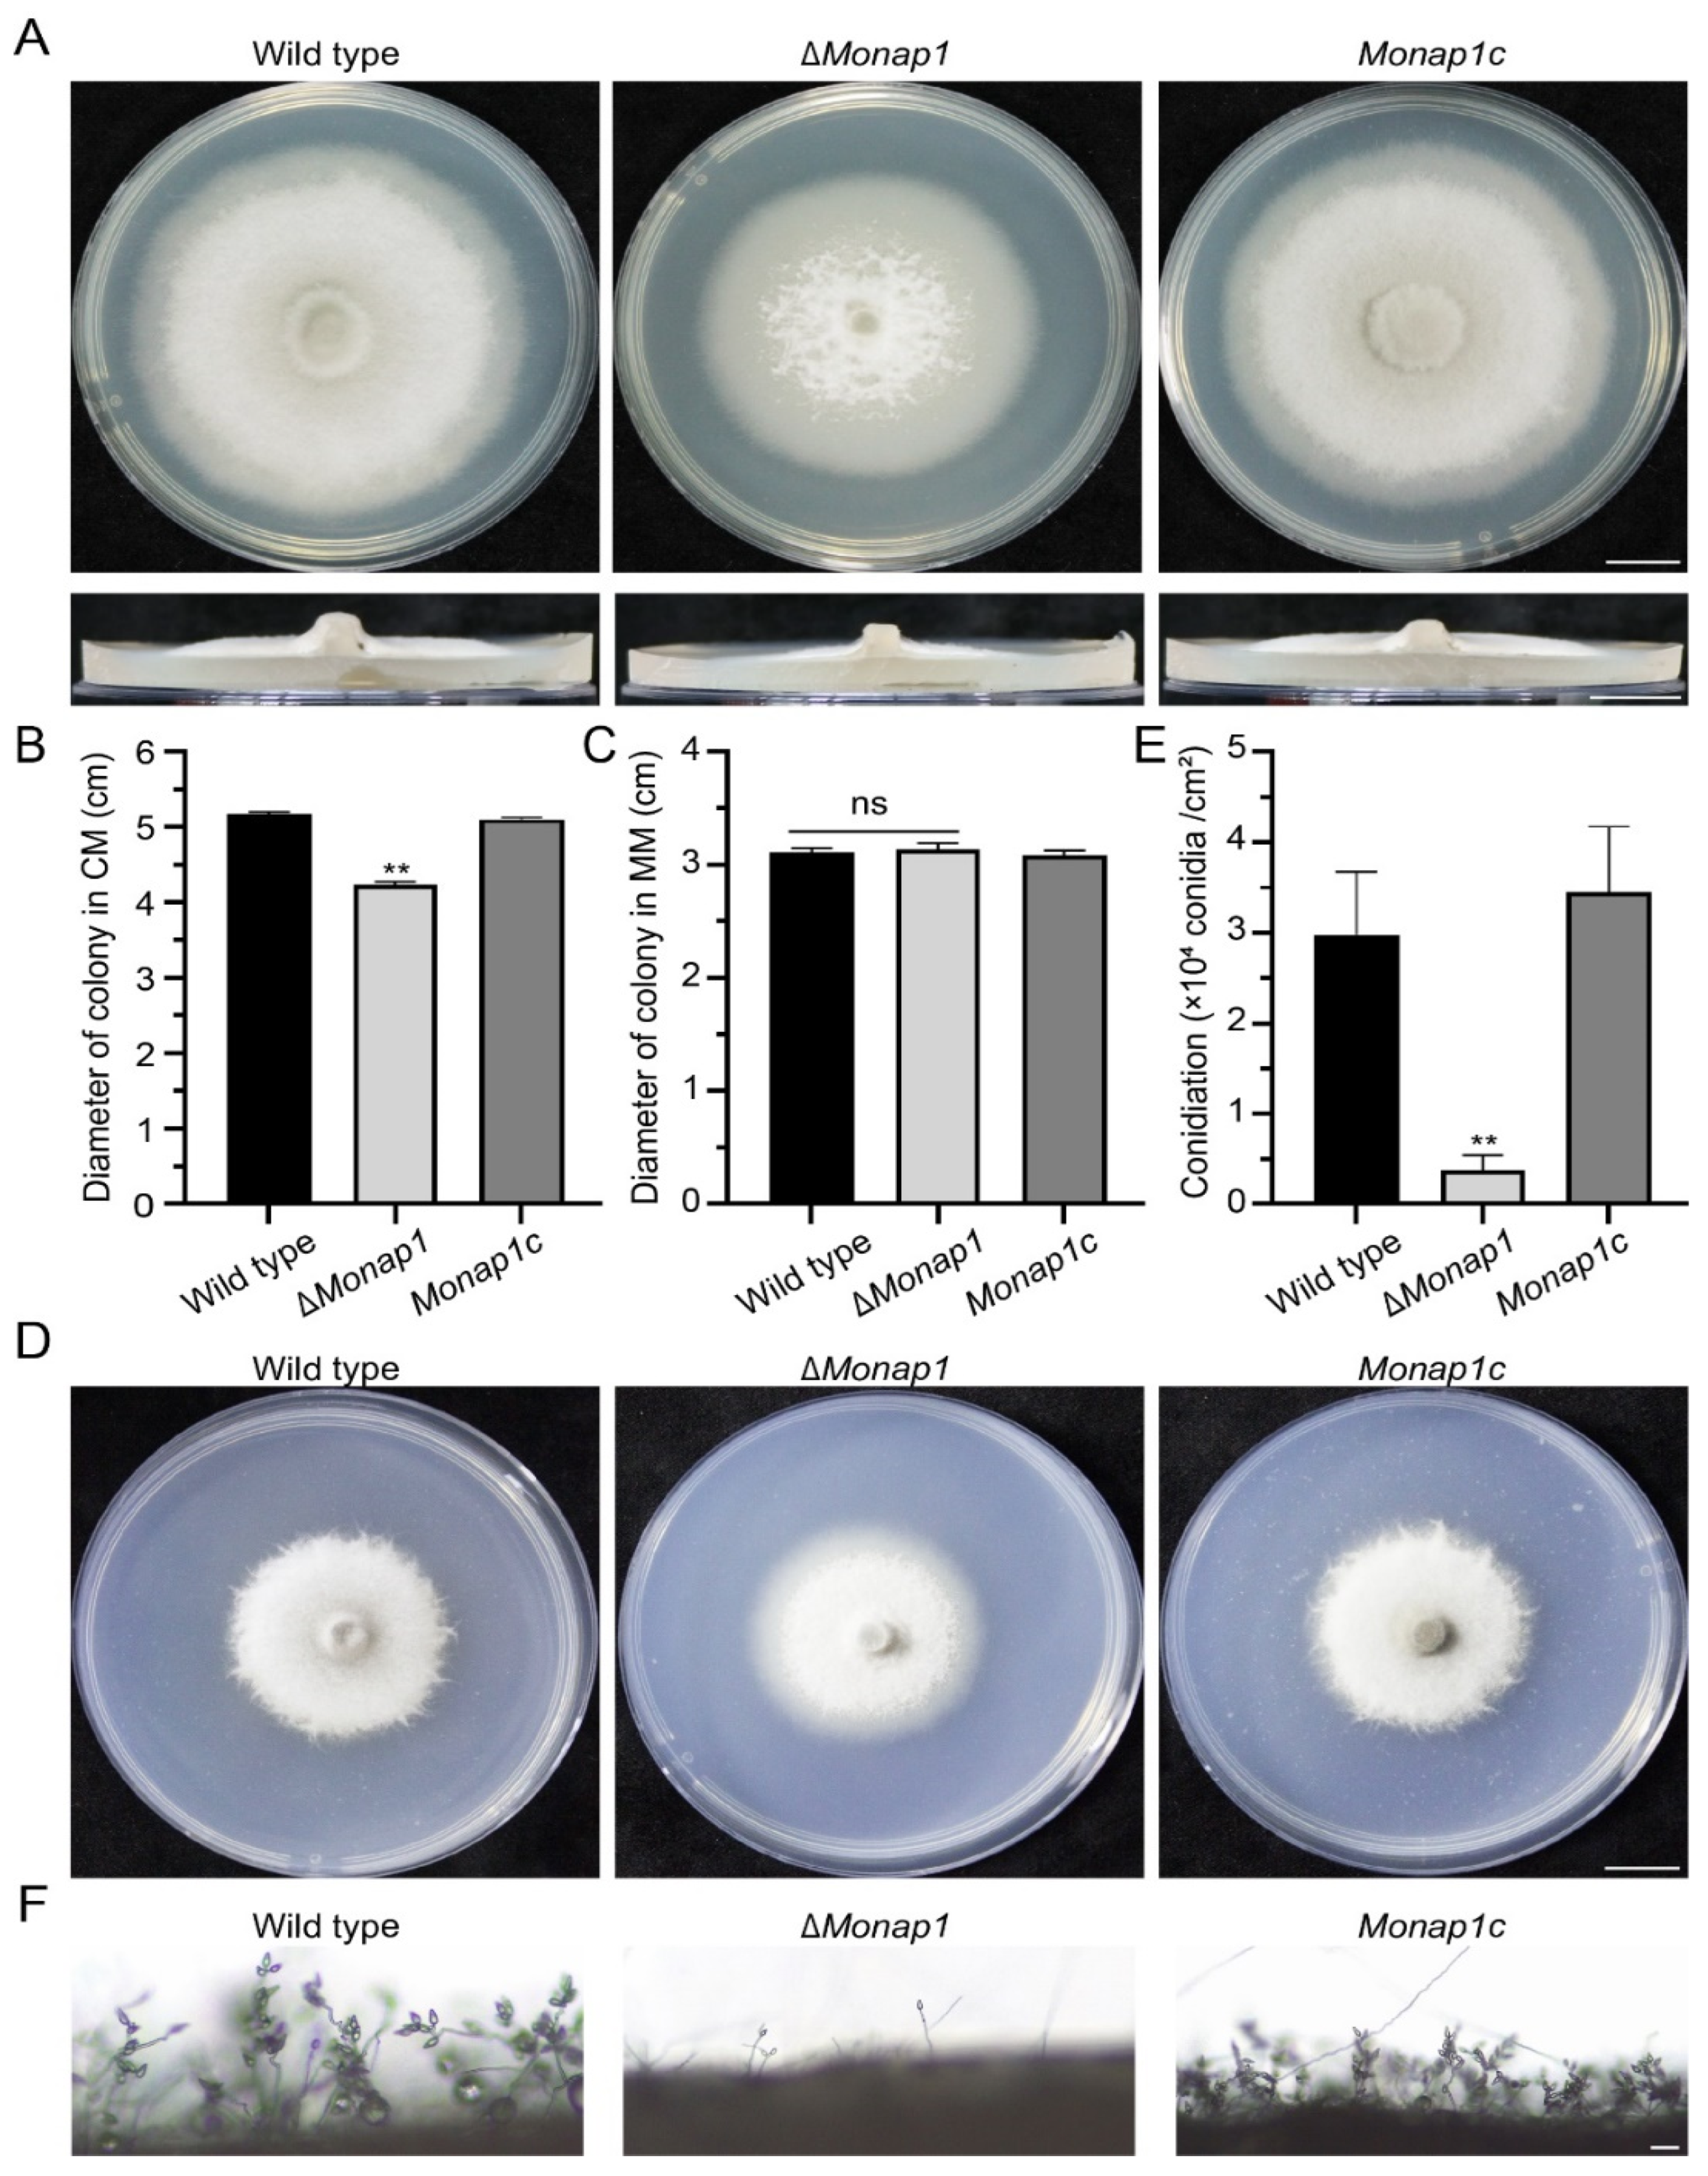
Ijms 23 07662 g002 Ijms 23 07662 g002

Nucleosome Assembly Protein 1, Nap1, Is Required for the Growth, Development, and Pathogenicity of Magnaporthe oryzae
Abstract
1. Introduction
2. Results
2.1. Identification and Targeted Gene Deletion of NAP1 in M. oryzae
2.2. NAP1 Is Involved in Sporulation and Appressorium Formation in M. oryzae
2.3. NAP1 Is Required for Virulence in M. oryzae
2.4. ∆Monap1 Is Sensitive to Cell Wall Integrity Stresses and Resistant to Microtubule Stresses
2.5. Nap1 Is Necessary for Proper Septin Ring Organization in M. oryzae
2.6. Nap1 Binds Histones H2A and H2B and G2/Mitotic-Specific B-Type Cyclin Cyc1 in M. oryzae
2.7. The NES of MoNap1 Is Dispensable for Localization and Binding the Histone Core Proteins H2A and H2B but Required for Growth and Pathogenicity
3. Discussion
4. Materials and Methods
4.1. Strains and Culture Conditions
4.2. Knockout of NAP1 in M. oryzae
4.3. Phenotypic Characterization
4.4. Observation of Fluorescence Fusion Proteins in M. oryzae
4.5. Pull-Down Assays and Bimolecular Fluorescence Complementation (BiFC) Assay
Supplementary Materials
Author Contributions
Funding
Institutional Review Board Statement
Informed Consent Statement
Data Availability Statement
Acknowledgments
Conflicts of Interest
References
- Talbot, N.J. On the Trail of a Cereal Killer: Exploring the Biology of Magnaporthe grisea. Annu. Rev. Microbiol. 2003, 57, 177–202. [Google Scholar] [CrossRef]
- Hamer, J.E.; Talbot, N.J. Infection-related development in the rice blast fungus Magnaporthe grisea. Curr. Opin. Microbiol. 1998, 1, 693–697. [Google Scholar] [CrossRef]
- Hamer, J.E.; Howard, R.J.; Chumley, F.G.; Valent, B. A Mechanism for Surface Attachment in Spores of a Plant Pathogenic Fungus. Science 1988, 239, 288–290. [Google Scholar] [CrossRef]
- De Jong, J.C.; McCormack, B.J.; Smirnoff, N.; Talbot, N.J. Glycerol generates turgor in rice blast. Nature 1997, 389, 244–245. [Google Scholar] [CrossRef]
- Gupta, L.; Vermani, M.; Ahluwalia, S.K.; Vijayaraghavan, P. Molecular virulence determinants of Magnaporthe oryzae: Disease pathogenesis and recent interventions for disease management in rice plant. Mycology 2021, 12, 174–187. [Google Scholar] [CrossRef]
- Ishimi, Y.; Kojima, M.; Yamada, M.-A.; Hanaoka, F. Binding mode of nucleosome-assembly protein (AP-I) and histones. Eur. J. Biochem. 1987, 162, 19–24. [Google Scholar] [CrossRef]
- Ishimi, Y.; Kikuchi, A. Identification and molecular cloning of yeast homolog of nucleosome assembly protein I which facilitates nucleosome assembly in vitro. J. Biol. Chem. 1991, 266, 7025–7029. [Google Scholar] [CrossRef]
- Mindrinos, M.; Katagiri, F.; Yu, G.-L.; Ausubel, F.M. The a-thaliana disease resistance gene RPS2 encodes a protein containing a nucleotide-binding site and leucine-rich repeats. Cell 1994, 78, 1089–1099. [Google Scholar] [CrossRef]
- Yoon, H.W.; Kim, M.C.; Lee, S.Y.; Hwang, I.; Bahk, J.D.; Hong, J.C.; Ishimi, Y.; Cho, M.J. Molecular cloning and functional characterization of a cDNA encoding nucleosome assembly protein 1 (NAP-1) from soybean. Mol. Gen. Genet. 1995, 249, 465–473. [Google Scholar] [CrossRef]
- Lankenau, S.; Barnickel, T.; Marhold, J.; Lyko, F.; Mechler, B.M.; Lankenau, D.-H. Knockout Targeting of the Drosophila Nap1 Gene and Examination of DNA Repair Tracts in the Recombination Products. Genetics 2003, 163, 611–623. [Google Scholar] [CrossRef]
- Rogner, U.C.; Spyropoulos, D.D.; Le Novère, N.; Changeux, J.-P.; Avner, P. Control of neurulation by the nucleosome assembly protein-1–like 2. Nat. Genet. 2000, 25, 431–435. [Google Scholar] [CrossRef]
- Dong, A.; Zhu, Y.; Yu, Y.; Cao, K.; Sun, C.; Shen, W.-H. Regulation of biosynthesis and intracellular localization of rice and tobacco homologues of nucleosome assembly protein 1. Planta 2003, 216, 561–570. [Google Scholar] [CrossRef]
- Ishimi, Y.; Hirosumi, J.; Sato, W.; Sugasawa, K.; Yokota, S.; Hanaoka, F.; Yamada, M.-A. Purification and initial characterization of a protein which facilitates assembly of nucleosome-like structure from mammalian cells. JBIC J. Biol. Inorg. Chem. 1984, 142, 431–439. [Google Scholar] [CrossRef]
- Andrews, A.J.; Downing, G.; Brown, K.; Park, Y.-J.; Luger, K. A Thermodynamic Model for Nap1-Histone Interactions. J. Biol. Chem. 2008, 283, 32412–32418. [Google Scholar] [CrossRef]
- Ohkuni, K.; Shirahige, K.; Kikuchi, A. Genome-wide expression analysis of NAP1 in Saccharomyces cerevisiae. Biochem. Biophys. Res. Commun. 2003, 306, 5–9. [Google Scholar] [CrossRef]
- Altman, R.; Kellogg, D. Control of Mitotic Events by Nap1 and the Gin4 Kinase. J. Cell Biol. 1997, 138, 119–130. [Google Scholar] [CrossRef]
- Asahara, H.; Tartare-Deckert, S.; Nakagawa, T.; Ikehara, T.; Hirose, F.; Hunter, T.; Ito, T.; Montminy, M. Dual Roles of p300 in Chromatin Assembly and Transcriptional Activation in Cooperation with Nucleosome Assembly Protein 1 In Vitro. Mol. Cell. Biol. 2002, 22, 2974–2983. [Google Scholar] [CrossRef]
- Huang, Z.-X.; Zhao, P.; Zeng, G.; Wang, Y.-M.; Sudbery, I.; Wang, Y. Phosphoregulation of Nap1 Plays a Role in Septin Ring Dynamics and Morphogenesis in Candida albicans. mBio 2014, 5, e00915-13. [Google Scholar] [CrossRef]
- Kellogg, D.R.; Murray, A.W. NAP1 acts with Clb2 to perform mitotic functions and to suppress polar bud growth in budding yeast. J. Cell Biol. 1995, 130, 675–685. [Google Scholar] [CrossRef]
- Miyaji-Yamaguchi, M.; Kato, K.; Nakano, R.; Akashi, T.; Kikuchi, A.; Nagata, K. Involvement of Nucleocytoplasmic Shuttling of Yeast Nap1 in Mitotic Progression. Mol. Cell. Biol. 2003, 23, 6672–6684. [Google Scholar] [CrossRef]
- Ito, T.; Bulger, M.; Kobayashi, R.; Kadonaga, J.T. Drosophila NAP-1 is a core histone chaperone that functions in ATP-facilitated assembly of regularly spaced nucleosomal arrays. Mol. Cell. Biol. 1996, 16, 3112–3124. [Google Scholar] [CrossRef]
- Rodrigueza, P.; Munroeb, D.; Prawittc, D.; Chu, L.L.; Bricb, E.; Kima, J.; Reid, L.H.; Daviese, C.; Nakagamaf, H.; Loebbertc, R.; et al. Functional Characterization of Human Nucleosome Assembly Protein-2 (NAP1L4) Suggests a Role as a Histone Chaperone. Genomics 1997, 44, 253–265. [Google Scholar] [CrossRef]
- Fujii-Nakata, T.; Ishimi, Y.; Okuda, A.; Kikuchi, A. Functional analysis of nucleosome assembly protein, NAP-1. The negatively charged COOH-terminal region is not necessary for the intrinsic assembly activity. J. Biol. Chem. 1992, 267, 20980–20986. [Google Scholar] [CrossRef]
- Li, M.; Strand, D.; Krehan, A.; Pyerin, W.; Heid, H.; Neumann, B.; Mechler, B.M. Casein kinase 2 binds and phosphorylates the nucleosome assembly protein-1 (NAP1) in Drosophila melanogaster. J. Mol. Biol. 1999, 293, 1067–1084. [Google Scholar] [CrossRef]
- McQuibban, G.A.; Commisso-Cappelli, C.N.; Lewis, P.N. Assembly, Remodeling, and Histone Binding Capabilities of Yeast Nucleosome Assembly Protein 1. J. Biol. Chem. 1998, 273, 6582–6590. [Google Scholar] [CrossRef]
- Lee, J.Y.; Lake, R.J.; Kirk, J.; Bohr, V.A.; Fan, H.-Y.; Hohng, S. NAP1L1 accelerates activation and decreases pausing to enhance nucleosome remodeling by CSB. Nucleic Acids Res. 2017, 45, 4696–4707. [Google Scholar] [CrossRef]
- Grande, M.; Lambea, E.; Fajardo, A.; López-Avilés, S.; Kellogg, D.; Aligue, R. Crosstalk between Nap1 protein and Cds1 checkpoint kinase to maintain chromatin integrity. Bba-Mol. Cell Res. 2008, 1783, 1595–1604. [Google Scholar] [CrossRef][Green Version]
- Sun, L.; Qian, H.; Liu, M.; Wu, M.; Wei, Y.; Zhu, X.; Lu, J.; Lin, F.; Liu, X. Endosomal sorting complexes required for transport-0 (ESCRT -0) are essential for fungal development, pathogenicity, autophagy and ER -phagy in Magnaporthe oryzae. Environ. Microbiol. 2022, 24, 1076–1092. [Google Scholar] [CrossRef]
- Osés-Ruiz, M.; Sakulkoo, W.; Littlejohn, G.R.; Martin-Urdiroz, M.; Talbot, N.J. Two independent S-phase checkpoints regulate appressorium-mediated plant infection by the rice blast fungus Magnaporthe oryzae. Proc. Natl. Acad. Sci. USA 2017, 114, E237–E244. [Google Scholar] [CrossRef]
- Li, L.; Zhu, X.-M.; Su, Z.-Z.; Del Poeta, M.; Liu, X.-H.; Lin, F.-C. Insights of roles played by septins in pathogenic fungi. Virulence 2021, 12, 1550–1562. [Google Scholar] [CrossRef]
- Aguilar-Gurrieri, C.; Larabi, A.; Vinayachandran, V.; Patel, N.A.; Yen, K.; Reja, R.; Ebong, I.; Schoehn, G.; Robinson, C.V.; Pugh, B.F.; et al. Structural evidence for Nap1-dependent H2A–H2B deposition and nucleosome assembly. EMBO J. 2016, 35, 1465–1482. [Google Scholar] [CrossRef]
- Dong, A.; Liu, Z.; Zhu, Y.; Yu, F.; Li, Z.; Cao, K.; Shen, W.-H. Interacting Proteins and Differences in Nuclear Transport Reveal Specific Functions for the NAP1 Family Proteins in Plants. Plant Physiol. 2005, 138, 1446–1456. [Google Scholar] [CrossRef]
- Osés-Ruiz, M.; Talbot, N.J. Cell cycle-dependent regulation of plant infection by the rice blast fungus Magnaporthe oryzae. Commun. Integr. Biol. 2017, 10, e1372067. [Google Scholar] [CrossRef]
- Toyoshima, F.; Moriguchi, T.; Wada, A.; Fukuda, M.; Nishida, E. Nuclear export of cyclin B1 and its possible role in the DNA damage-induced G2 checkpoint. EMBO J. 1998, 17, 2728–2735. [Google Scholar] [CrossRef]
- Odenbach, D.; Breth, B.; Thines, E.; Weber, R.W.S.; Anke, H.; Foster, A.J. The transcription factor Con7p is a central regulator of infection-related morphogenesis in the rice blast fungus Magnaporthe grisea. Mol. Microbiol. 2007, 64, 293–307. [Google Scholar] [CrossRef]
- Lu, J.-P.; Cao, H.; Zhang, L.; Huang, P.; Lin, F. Systematic Analysis of Zn2Cys6 Transcription Factors Required for Development and Pathogenicity by High-Throughput Gene Knockout in the Rice Blast Fungus. PLOS Pathog. 2014, 10, e1004432. [Google Scholar] [CrossRef]
- Qu, Y.; Wang, J.; Zhu, X.; Dong, B.; Liu, X.; Lu, J.; Lin, F. The P5-type ATPase Spf1 is required for development and virulence of the rice blast fungus Pyricularia oryzae. Curr. Genet. 2020, 66, 385–395. [Google Scholar] [CrossRef]
- Lu, J.-P.; Liu, X.-H.; Feng, X.-X.; Min, H.; Lin, F.-C. An autophagy gene, MgATG5, is required for cell differentiation and pathogenesis in Magnaporthe oryzae. Curr. Genet. 2009, 55, 461–473. [Google Scholar] [CrossRef]
- Patkar, R.N.; Suresh, A.; Naqvi, N.I. MoTea4-Mediated Polarized Growth Is Essential for Proper Asexual Development and Pathogenesis in Magnaporthe oryzae. Eukaryot. Cell 2010, 9, 1029–1038. [Google Scholar] [CrossRef]
- Huang, P.; Cao, H.; Li, Y.; Zhu, S.; Wang, J.; Wang, Q.; Liu, X.; Lin, F.-C.; Lu, J. Melanin Promotes Spore Production in the Rice Blast Fungus Magnaporthe oryzae. Front. Microbiol. 2022, 13, 843838. [Google Scholar] [CrossRef]
- Dulal, N.; Rogers, A.M.; Proko, R.; Bieger, B.D.; Liyanage, R.; Krishnamurthi, V.R.; Wang, Y.; Egan, M.J. Turgor-dependent and coronin-mediated F-actin dynamics drive septin disc-to-ring remodeling in the blast fungus Magnaporthe oryzae. J. Cell Sci. 2021, 134, jcs251298. [Google Scholar] [CrossRef]
- Gupta, Y.K.; Dagdas, Y.F.; Martinez-Rocha, A.L.; Kershaw, M.J.; Littlejohn, G.R.; Ryder, L.S.; Sklenar, J.; Menke, F.; Talbot, N.J. Septin-Dependent Assembly of the Exocyst Is Essential for Plant Infection by Magnaporthe oryzae. Plant Cell 2015, 27, 3277–3289. [Google Scholar] [CrossRef]
- Spiliotis, E.T. Regulation of microtubule organization and functions by septin GTPases. Cytoskeleton 2010, 67, 339–345. [Google Scholar] [CrossRef]
- Sellin, M.E.; Holmfeldt, P.; Stenmark, S.; Gullberg, M. Microtubules support a disk-like septin arrangement at the plasma membrane of mammalian cells. Mol. Biol. Cell 2011, 22, 4588–4601. [Google Scholar] [CrossRef]
- Hoyt, M.; Totis, L.; Roberts, B.S. cerevisiae genes required for cell cycle arrest in response to loss of microtubule function. Cell 1991, 66, 507–517. [Google Scholar] [CrossRef]
- Qu, Y.; Cao, H.; Huang, P.; Wang, J.; Liu, X.; Lu, J.; Lin, F.-C. A kelch domain cell end protein, PoTea1, mediates cell polarization during appressorium morphogenesis in Pyricularia oryzae. Microbiol. Res. 2022, 259, 126999. [Google Scholar] [CrossRef]
- Zachleder, V.; Ivanov, I.; Vítová, M.; Bišová, K. Cell Cycle Arrest by Supraoptimal Temperature in the Alga Chlamydomonas reinhardtii. Cells 2019, 8, 1237. [Google Scholar] [CrossRef]
- Osmani, S.A.; Engle, D.B.; Doonan, J.; Morris, N. Spindle formation and chromatin condensation in cells blocked at interphase by mutation of a negative cell cycle control gene. Cell 1988, 52, 241–251. [Google Scholar] [CrossRef]
- Saunders, D.G.; Aves, S.J.; Talbot, N.J. Cell Cycle–Mediated Regulation of Plant Infection by the Rice Blast Fungus. Plant Cell 2010, 22, 497–507. [Google Scholar] [CrossRef]
- Wessels, J.G.H. Developmental regulation of fungal cell wall formation. Annu. Rev. Phytopathol. 1994, 32, 413–437. [Google Scholar] [CrossRef]
- Sun, D.; Cao, H.; Shi, Y.; Huang, P.; Dong, B.; Liu, X.; Lin, F.; Lu, J. The regulatory factor X protein MoRfx1 is required for development and pathogenicity in the rice blast fungus Magnaporthe oryzae. Mol. Plant Pathol. 2017, 18, 1075–1088. [Google Scholar] [CrossRef]
- Ram, A.F.J.; Klis, F.M. Identification of fungal cell wall mutants using susceptibility assays based on Calcofluor white and Congo red. Nat. Protoc. 2006, 1, 2253–2256. [Google Scholar] [CrossRef]
- Hecht, S.M. Bleomycin: New Perspectives on the Mechanism of Action. J. Nat. Prod. 2000, 63, 158–168. [Google Scholar] [CrossRef]
- Beaudouin, R.; Lim, S.T.; Steide, J.A.; Powell, M.; McKoy, J.; Pramanik, A.J.; Johnson, E.; Moore, C.W.; Lipke, P.N. Bleomycin affects cell wall anchorage of mannoproteins in Saccharomyces cerevisiae. Antimicrob. Agents Chemother. 1993, 37, 1264–1269. [Google Scholar] [CrossRef]
- Lim, S.T.; Jue, C.K.; Moore, C.W.; Lipke, P. Oxidative cell wall damage mediated by bleomycin-Fe(II) in Saccharomyces cerevisiae. J. Bacteriol. 1995, 177, 3534–3539. [Google Scholar] [CrossRef][Green Version]
- Moore, C.W.; McKoy, J.; Del Valle, R.; Armstrong, D.; Bernard, E.M.; Katz, N.; Gordon, R.E. Fungal Cell Wall Septation and Cytokinesis Are Inhibited by Bleomycins. Antimicrob. Agents Chemother. 2003, 47, 3281–3289. [Google Scholar] [CrossRef]
- Zhu, Y.; Dong, A.; Meyer, D.; Pichon, O.; Renou, J.-P.; Cao, K.; Shen, W.-H. Arabidopsis NRP1 and NRP2 Encode Histone Chaperones and Are Required for Maintaining Postembryonic Root Growth. Plant Cell 2006, 18, 2879–2892. [Google Scholar] [CrossRef]
- Mosammaparast, N.; Ewart, C.S.; Pemberton, L.F. A role for nucleosome assembly protein 1 in the nuclear transport of histones H2A and H2B. EMBO J. 2002, 21, 6527–6538. [Google Scholar] [CrossRef]
- Calvert, M.E.K.; Keck, K.M.; Ptak, C.; Shabanowitz, J.; Hunt, D.F.; Pemberton, L.F. Phosphorylation by Casein Kinase 2 Regulates Nap1 Localization and Function. Mol. Cell. Biol. 2008, 28, 1313–1325. [Google Scholar] [CrossRef][Green Version]
- Mosammaparast, N.; Jackson, K.R.; Guo, Y.; Brame, C.J.; Shabanowitz, J.; Hunt, D.F.; Pemberton, L.F. Nuclear Import of Histone H2a and H2b Is Mediated by a Network of Karyopherins. J. Cell Biol. 2001, 153, 251–262. [Google Scholar] [CrossRef]
- Talbot, N.J.; Ebbole, D.J.; Hamer, J.E. Identification and characterization of MPG1, a gene involved in pathogenicity from the rice blast fungus Magnaporthe grisea. Plant Cell 1993, 5, 1575–1590. [Google Scholar] [CrossRef] [PubMed]
- Yan, Y.; Wang, H.; Zhu, S.; Wang, J.; Liu, X.; Lin, F.; Lu, J. The Methylcitrate Cycle Is Required for Development and Virulence in the Rice Blast Fungus Pyricularia oryzae. Mol. Plant-Microbe Interact. 2019, 32, 1148–1161. [Google Scholar] [CrossRef] [PubMed]
- Zhu, S.; Yan, Y.; Qu, Y.; Wang, J.; Feng, X.; Liu, X.; Lin, F.; Lu, J. Role refinement of melanin synthesis genes by gene knockout reveals their functional diversity in Pyricularia oryzae strains. Microbiol. Res. 2020, 242, 126620. [Google Scholar] [CrossRef] [PubMed]
- Lu, J.-P.; Feng, X.-X.; Liu, X.-H.; Lu, Q.; Wang, H.-K.; Lin, F.-C. Mnh6, a nonhistone protein, is required for fungal development and pathogenicity of Magnaporthe grisea. Fungal Genet. Biol. 2007, 44, 819–829. [Google Scholar] [CrossRef]
- Cao, H.; Huang, P.; Zhang, L.; Shi, Y.; Sun, D.; Yan, Y.; Liu, X.; Dong, B.; Chen, G.; Snyder, J.H.; et al. Characterization of 47 Cys2 -His2 zinc finger proteins required for the development and pathogenicity of the rice blast fungus Magnaporthe oryzae. New Phytol. 2016, 211, 1035–1051. [Google Scholar] [CrossRef] [PubMed]
- Liu, T.-B.; Liu, X.-H.; Lu, J.-P.; Zhang, L.; Min, H.; Lin, F.-C. The cysteine protease MoAtg4 interacts with MoAtg8 and is required for differentiation and pathogenesis in Magnaporthe oryzae. Autophagy 2010, 6, 74–85. [Google Scholar] [CrossRef]

Publisher’s Note: MDPI stays neutral with regard to jurisdictional claims in published maps and institutional affiliations. |
© 2022 by the authors. Licensee MDPI, Basel, Switzerland. This article is an open access article distributed under the terms and conditions of the Creative Commons Attribution (CC BY) license (https://creativecommons.org/licenses/by/4.0/).
Share and Cite
Wang, Q.; Wang, J.; Huang, P.; Huang, Z.; Li, Y.; Liu, X.; Lin, F.; Lu, J. Nucleosome Assembly Protein 1, Nap1, Is Required for the Growth, Development, and Pathogenicity of Magnaporthe oryzae. Int. J. Mol. Sci. 2022, 23, 7662. https://doi.org/10.3390/ijms23147662
Wang Q, Wang J, Huang P, Huang Z, Li Y, Liu X, Lin F, Lu J. Nucleosome Assembly Protein 1, Nap1, Is Required for the Growth, Development, and Pathogenicity of Magnaporthe oryzae. International Journal of Molecular Sciences. 2022; 23(14):7662. https://doi.org/10.3390/ijms23147662
Chicago/Turabian StyleWang, Qing, Jing Wang, Pengyun Huang, Zhicheng Huang, Yan Li, Xiaohong Liu, Fucheng Lin, and Jianping Lu. 2022. "Nucleosome Assembly Protein 1, Nap1, Is Required for the Growth, Development, and Pathogenicity of Magnaporthe oryzae" International Journal of Molecular Sciences 23, no. 14: 7662. https://doi.org/10.3390/ijms23147662
APA StyleWang, Q., Wang, J., Huang, P., Huang, Z., Li, Y., Liu, X., Lin, F., & Lu, J. (2022). Nucleosome Assembly Protein 1, Nap1, Is Required for the Growth, Development, and Pathogenicity of Magnaporthe oryzae. International Journal of Molecular Sciences, 23(14), 7662. https://doi.org/10.3390/ijms23147662

